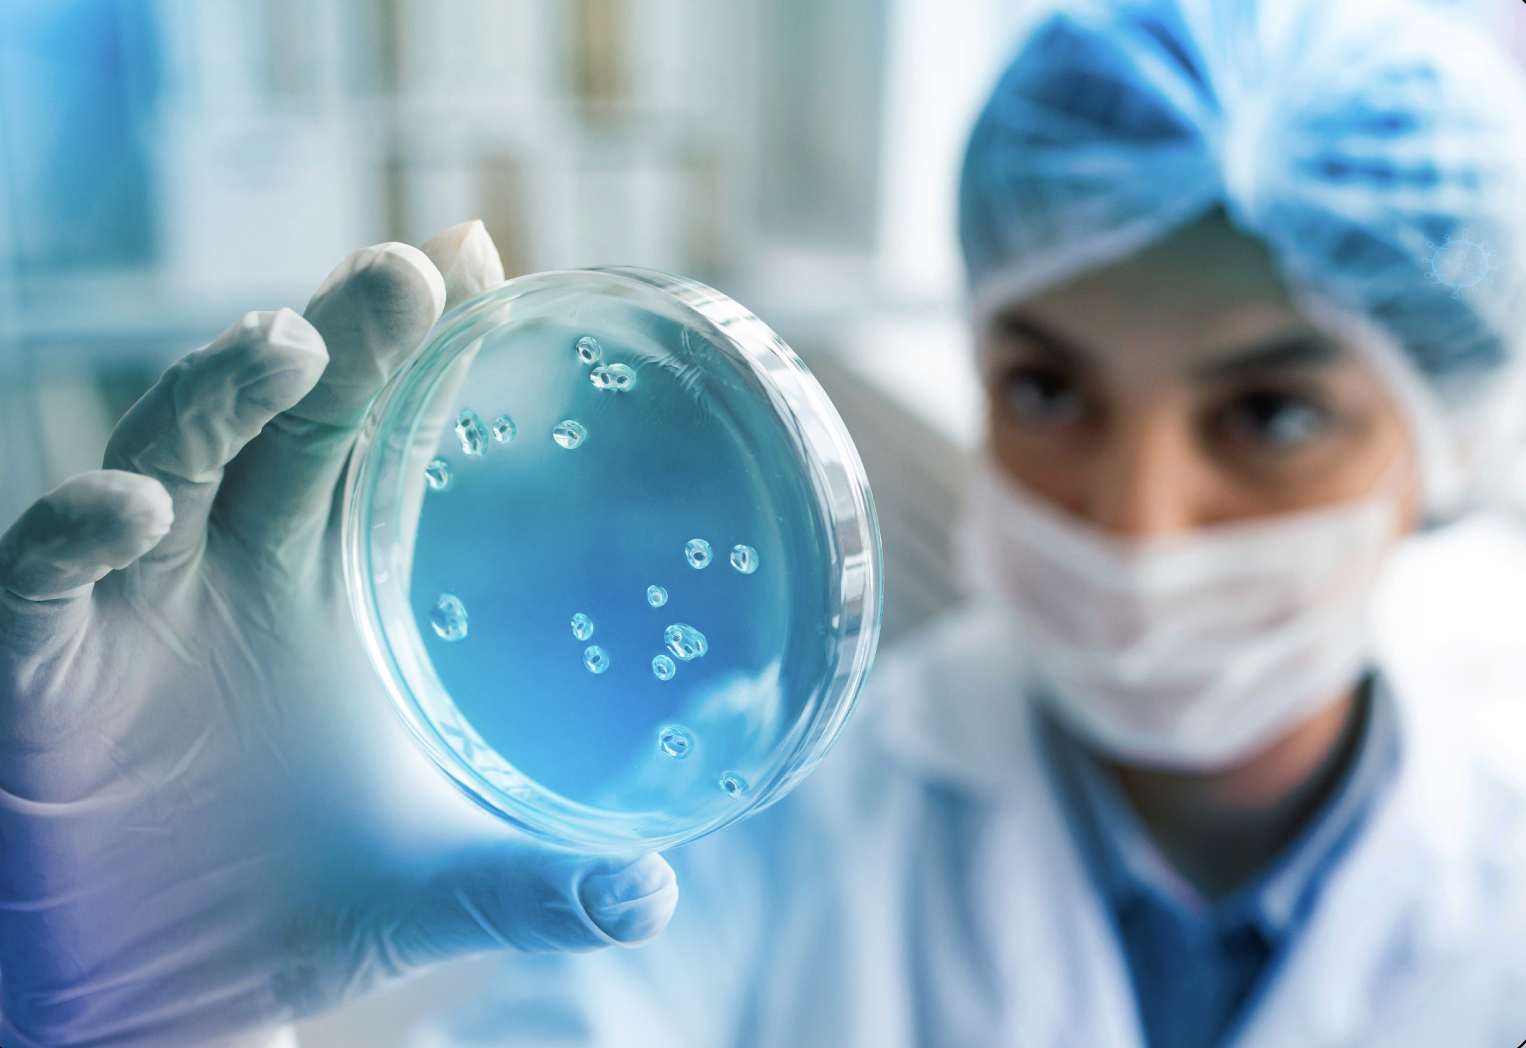

ABOUT US
Saffron Holistic Health Care Pvt Ltd is a pioneer in the hygiene, disinfectant, and antiseptic product category, dedicated to delivering superior quality and protection. Our products are proudly manufactured in a state-of-the-art facility, certified by FDA, CGMP, and ISO, ensuring world-class standards in every drop.
During the COVID-19 pandemic, our flagship brands MY CARE+ and OMNI PROTECT+ emerged as some of the fastest-growing hygiene solutions, quickly gaining trust across the region to become a household name in infection prevention.
Today, OMNI PROTECT+ is expanding into a broader and more advanced range of antiseptic, disinfectant, and hygiene products, committed to safeguarding health with holistic innovation.
At the heart of our journey lies our unwavering focus on
- Quality
- Service
- Assurance of 100% Protection
At the heart of our journey lies our unwavering focus on

QUALITY

SERVICE

ASSURANCE
We dont just offer products—we offer protection you can trust
OUR VISION
OMNI PROTECT+ proudly emerges as a “Made in India” brand with a global outlook—crafted to meet international standards and cater to global healthcare needs.
We are committed to:
- Delivering quality-driven solutions
- Ensuring assured, safe protection
- Championing a holistic approach to health care
With innovation, integrity, and care at our core, we aim to be a trusted name in infection control and hygiene, both in India and across the world.
At OMNI PROTECT+, our mission is to deliver sustainable healthcare, hygiene, and infection control solutions that meet global standards while addressing region-specific needs.
We are driven by innovation and science-backed formulations, making them the cornerstone of our product philosophy. Our goal is to provide cutting-edge solutions that ensure:
- Complete safety and efficacy
- Alignment with emerging needs in the health and wellness sector
- Excellence in both products and services
- Through a holistic approach, we aim to empower communities with reliable, future-ready protection that supports long-term well-being.


OUR MISSION
At OMNI PROTECT+, our mission is to deliver sustainable healthcare, hygiene, and infection control solutions that meet global standards while addressing region-specific needs.
We are driven by innovation and science-backed formulations, making them the cornerstone of our product philosophy. Our goal is to provide cutting-edge solutions that ensure:
- Complete safety and efficacy
- Alignment with emerging needs in the health and wellness sector
- Excellence in both products and services
- Through a holistic approach, we aim to empower communities with reliable, future-ready protection that supports long-term well-being.
